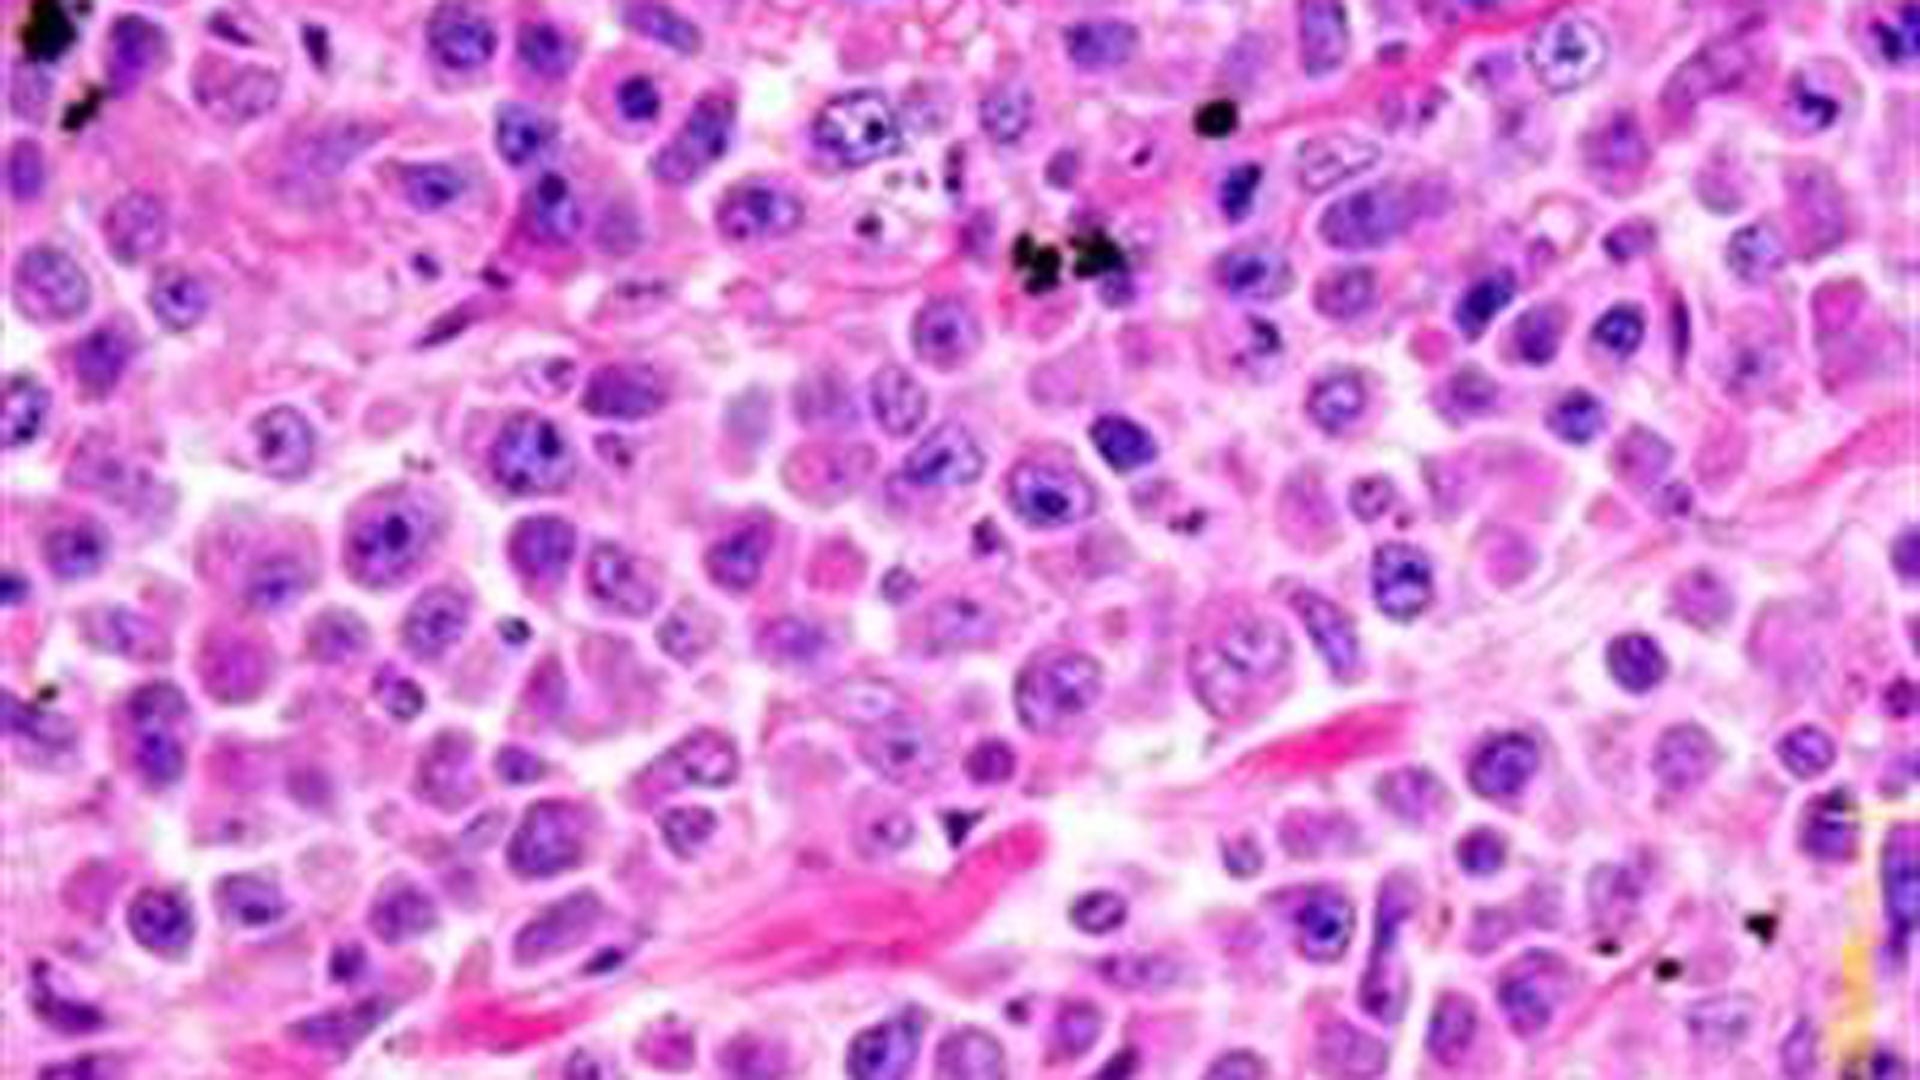
La leucemia mieloide aguda es un cáncer agresivo y letal que puede desarrollarse en cuestión de días y afecta a la sangre y la médula ósea

La revelación sobre el estado de salud de Tatiana Schlossberg, nieta del expresidente John F. Kennedy, ha causado una fuerte impresión en la opinión pública estadounidense. A través de un emotivo ensayo publicado en la revista The New Yorker, Schlossberg compartió la noticia que fue diagnosticada con leucemia mieloide aguda (LMA) poco después de dar a luz a su segundo hijo.
Con 35 años, y perteneciendo a una de las familias más conocidas de Estados Unidos, su testimonio atrajo inmediatamente la atención tanto de los medios como de la comunidad médica. La sinceridad del relato permitió a muchos conocer de cerca el desarrollo de una enfermedad que, debido a su agresividad y letalidad, suele permanecer en el ámbito de la noticia médica especializada.
Según Schlossberg, el diagnóstico fue un golpe inesperado. Aunque se consideraba una persona extremadamente saludable, al finalizar su embarazo en mayo de 2024, los médicos detectaron un número anormalmente alto de glóbulos blancos en su sangre, lo que derivó en pruebas más detalladas y, finalmente, en la confirmación de esta grave afección. Su experiencia personal ha servido para poner un rostro humano a una enfermedad que afecta a miles de personas anónimas cada año, sumando una nueva voz relevante al debate público sobre el cáncer y la investigación biomédica.
Al respecto, Vijay Sankaran, médico del Instituto Oncológico Dana-Farber, consideró: “Proviene de una familia muy prominente, pero cualquiera puede verse afectado por el cáncer, incluso personas jóvenes que parecen sanas”.
Características y peligrosidad de la leucemia mieloide aguda
La leucemia mieloide aguda es un tipo de cáncer que se desenvuelve rápidamente y que afecta tanto a la médula ósea como a la sangre. Los expertos consultados por medios estadounidenses destacan que la LMA puede desarrollarse en cuestión de días, desde ser indetectable a comprometer millones de células, lo que la hace especialmente peligrosa. Contrario a lo que muchos imaginan, esta enfermedad no responde necesariamente a factores de riesgo clásicos, y puede presentarse en personas jóvenes y aparentemente sin antecedentes relevantes para el cáncer.
Sankaran enfatiza que la LMA es relativamente poco común, con aproximadamente cuatro casos nuevos por cada 100.000 adultos al año. Sin embargo, su carácter impredecible y su agresividad la convierten en una de las formas de leucemia más difíciles de tratar. Según expresó, “uno de los peligros de las leucemias mieloides agudas es que pueden aparecer de forma repentina, pasando de ser indetectables a afectar a cientos de células en cuestión de días”. Debido a su rápida propagación y a los síntomas iniciales poco específicos, el diagnóstico a menudo se produce en etapas avanzadas, lo que reduce las posibilidades de una respuesta favorable a los tratamientos disponibles.
Subtipo específico: Anomalía cromosómica Inversión 3 y su rareza

El subtipo de leucemia que enfrenta Tatiana Schlossberg incluye una anomalía cromosómica conocida anteriormente como Inversión 3. Este subtipo afecta solo al 1-2% de los casos de LMA, lo que lo convierte en una forma extremadamente rara de la enfermedad. La existencia de esta mutación genética complica todavía más el pronóstico, ya que se trata de una variante para la cual casi no existen terapias efectivas reconocidas en la actualidad.
La profesora Courtney DiNardo, del Centro Oncológico MD Anderson, señaló sobre la Inversión 3: “Es uno de los pocos subtipos de leucemia mieloide aguda para los que existen pocas terapias eficaces, lo que significa que las remisiones o curaciones son la minoría”.
Esta especificidad genética agrava la situación de Schlossberg, pues las particularidades de la Inversión 3 hacen que los tipos de quimioterapia y trasplantes habituales en otros subtipos de LMA resulten mucho menos efectivos, lo que limita seriamente las opciones terapéuticas y reduce drásticamente la esperanza de vida tras el diagnóstico.
Opciones de tratamiento y experiencia de Schlossberg
Después del diagnóstico, Schlossberg fue sometida a los principales tratamientos disponibles, incluyendo quimioterapia intensiva, trasplante de médula ósea y la participación en ensayos clínicos experimentales. En su testimonio, describe el impacto físico y emocional de estos tratamientos, que incluyeron la extracción de sangre de su hermana y la pérdida de su cabello tras las sesiones de quimioterapia.
También participó en un ensayo clínico de terapia celular CAR-T, una inmunoterapia revolucionaria que ha mostrado excelentes resultados en otras leucemias, aunque su eficacia en la LMA aún resulta muy limitada. Sankaran agregó que “aunque la terapia ha sido revolucionaria para otros tipos de leucemia, no lo es tanto para la leucemia mieloide aguda”.

A pesar de intentar todos los recursos médicos disponibles, los especialistas indicaron a Schlossberg que, con la terapia experimental, su expectativa de vida podría ampliarse, en el mejor de los casos, hasta un año adicional: “En el último ensayo clínico, su médico le dijo a Schlossberg que podría ‘mantenerme con vida durante un año, tal vez’”, según recoge su ensayo. Esta realidad demuestra la urgencia de avanzar en investigación biomédica, especialmente para los subtipos más raros y resistentes de cáncer de sangre.
Impacto del caso en la concienciación y llamado a impulsar la investigación
El caso de Tatiana Schlossberg, pese a su acceso privilegiado a atención médica de alta calidad, evidencia las limitaciones de la ciencia médica ante ciertos tipos de cáncer. Expertos como Sankaran recalcan que, si incluso quienes cuentan con los mejores recursos enfrentan pronósticos tan adversos, existe una clara necesidad de ampliar la inversión en investigación y en el desarrollo de nuevas terapias. “Sigue teniendo un pronóstico desfavorable incluso con las mejores herramientas disponibles que tenemos, por lo que creo que esto solo pone de relieve nuestra necesidad de mejorar para muchos de nuestros pacientes”, concluyó Sankaran.
